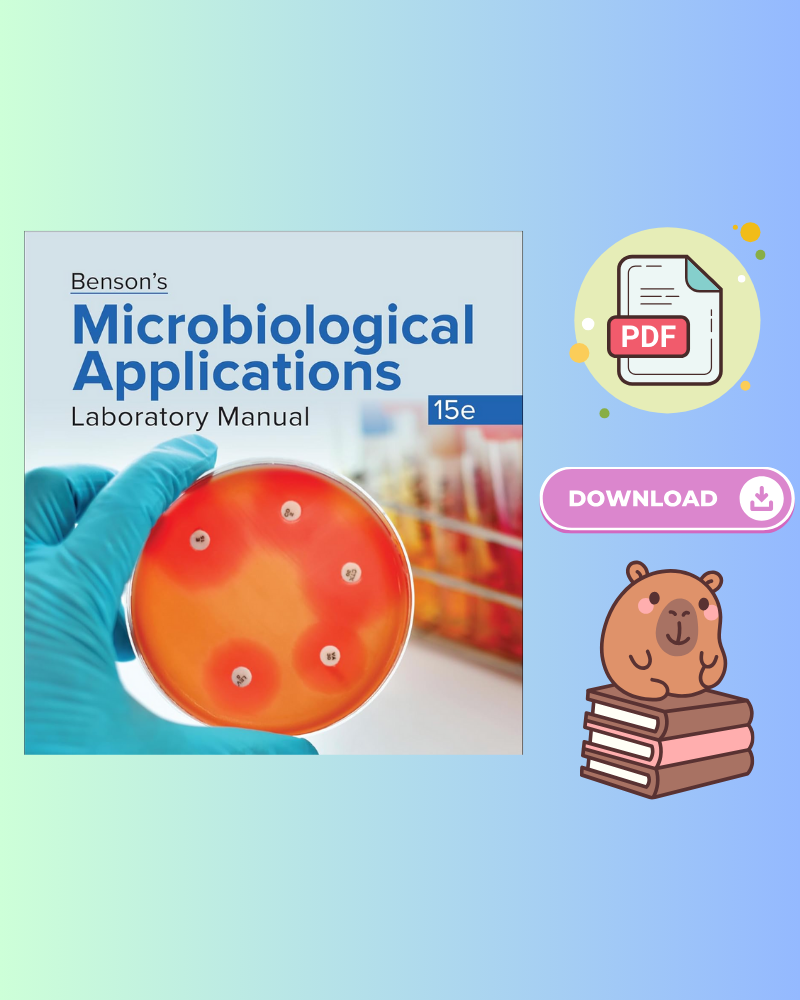

~The Study Lounge~
Welcome to The Study Lounge!
Passionate about empowering learning and expanding knowledge in every way possible. We understand that textbooks can be quite a significant expense, so our mission is to make education more accessible by offering high quality digital textbooks at the most affordable prices. Whether you’re a student striving for academic success or a lifelong learner, we’re here to support your journey with cost effective solutions.
Can’t find a specific textbook? Send us a message, and we’ll do our best to help you get the materials you need. Check out our collection and take the next step toward achieving your educational goals!